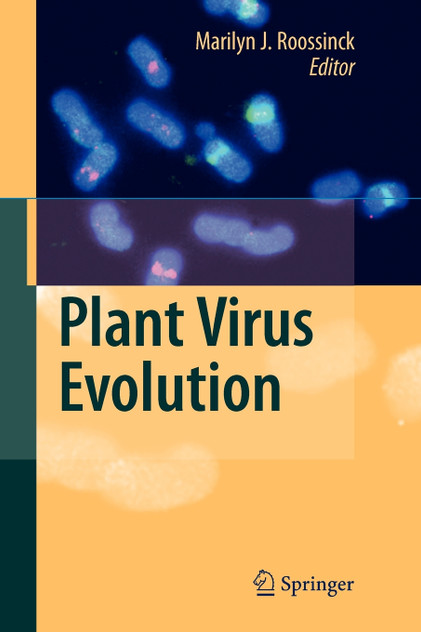

Plant Virus Evolution
Discover your next great read at BookLoop, Australia's trusted online bookstore offering a vast selection of titles across various genres and interests. Whether you're curious about what's trending or searching for graphic novels that captivate, thrilling crime and mystery fiction, or exhilarating action and adventure stories, our curated collections have something for every reader. Delve into imaginative fantasy worlds or explore the realms of science fiction that challenge the boundaries of reality.
For those with a green thumb, our comprehensive range of gardening books provides insights and tips for all levels of enthusiasts. If you're aiming to enhance your financial acumen, our selection of finance, business, and management books offers valuable knowledge from industry experts. Craft lovers will appreciate our assortment of handicrafts, decorative arts, and crafts books, perfect for inspiring your next project. Engage your mind with our collection of hobbies, quizzes, and games books, or explore the mystical with our fortune-telling and divination guides.
Transportation aficionados can immerse themselves in our extensive transportation books, including detailed works on road and motor vehicles. Young readers are not left out, with a delightful array of picture books and early learning concepts designed to educate and entertain. Fans of contemporary narratives will find compelling stories in our contemporary fiction section. Embark on epic journeys with our fantasy and science fiction titles, or gain inspiration from real-life tales in our biographies and true stories collection. Health-conscious readers can explore our health and wholefood cooking books, focusing on specific diets and conditions.
BookLoop proudly supports the educational needs of students and schools across Australia. Our textbook collection includes school books and teacher resources for every phase from primary school books, secondary school books, and essential titles for TAFE courses, vocational training, and university study. Each book is selected to align with curriculum outcomes and classroom needs, making it easy for schools and teachers to plan ahead.
From structured lesson planning to engaging student activities, our wide range of school books and teacher resources provides essential tools for educators. You’ll also find dedicated school and preschool teacher materials designed for early years education, classroom support, and intervention. Teachers can access a reliable selection of workbooks, literacy and numeracy programs, assessment tools, and professional development guides all in one place.
Support the earliest stages of education with our curated range of early childhood care and education books. These titles are ideal for early learning centres, preschools, and childcare settings, offering age-appropriate resources that build foundational skills in literacy, numeracy, and emotional development. Families and educators alike trust our resources for quality, clarity, and classroom effectiveness.
We make bulk school book orders simple and efficient. Schools, libraries, and early learning centres can rely on BookLoop for competitive pricing, fast shipping, and expert support when sourcing large quantities of textbooks and educational materials. Whether you’re restocking for a new term or ordering resources for an entire class, our bulk ordering system ensures convenience and accuracy every step of the way.
Explore our new releases for the most recent additions in romance books, fantasy books, graphic novels, crime and mystery books, science fiction books as well as biographies, cookbooks, self help books, tarot cards, fortunetelling and much more. With titles covering current trends, booktok and bookstagram recommendations, and emerging authors, BookLoop remains your go-to local australian bookstore for buying books online across all book genres.
Stay updated with the literary world by browsing our trending books, featuring the latest bestsellers and critically acclaimed works. Explore titles from popular brands like Minecraft, Pokemon, Star Wars, Bluey, Lonely Planet, ABIA award winners, Peppa Pig, and our specialised collection of ADHD books. At BookLoop, we are committed to providing a diverse and enriching reading experience for all.
If you have any questions before making a purchase chat with our online operators to get more information.
or find our Questions & Answers